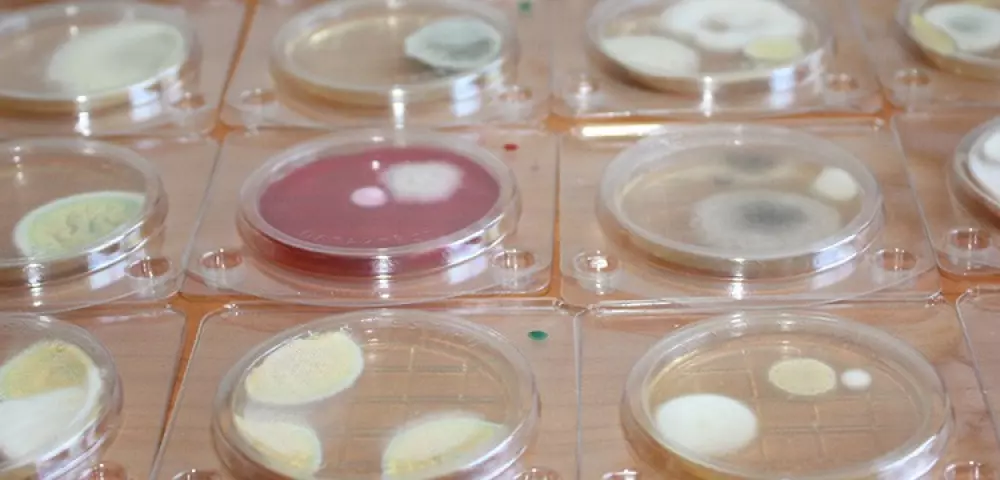
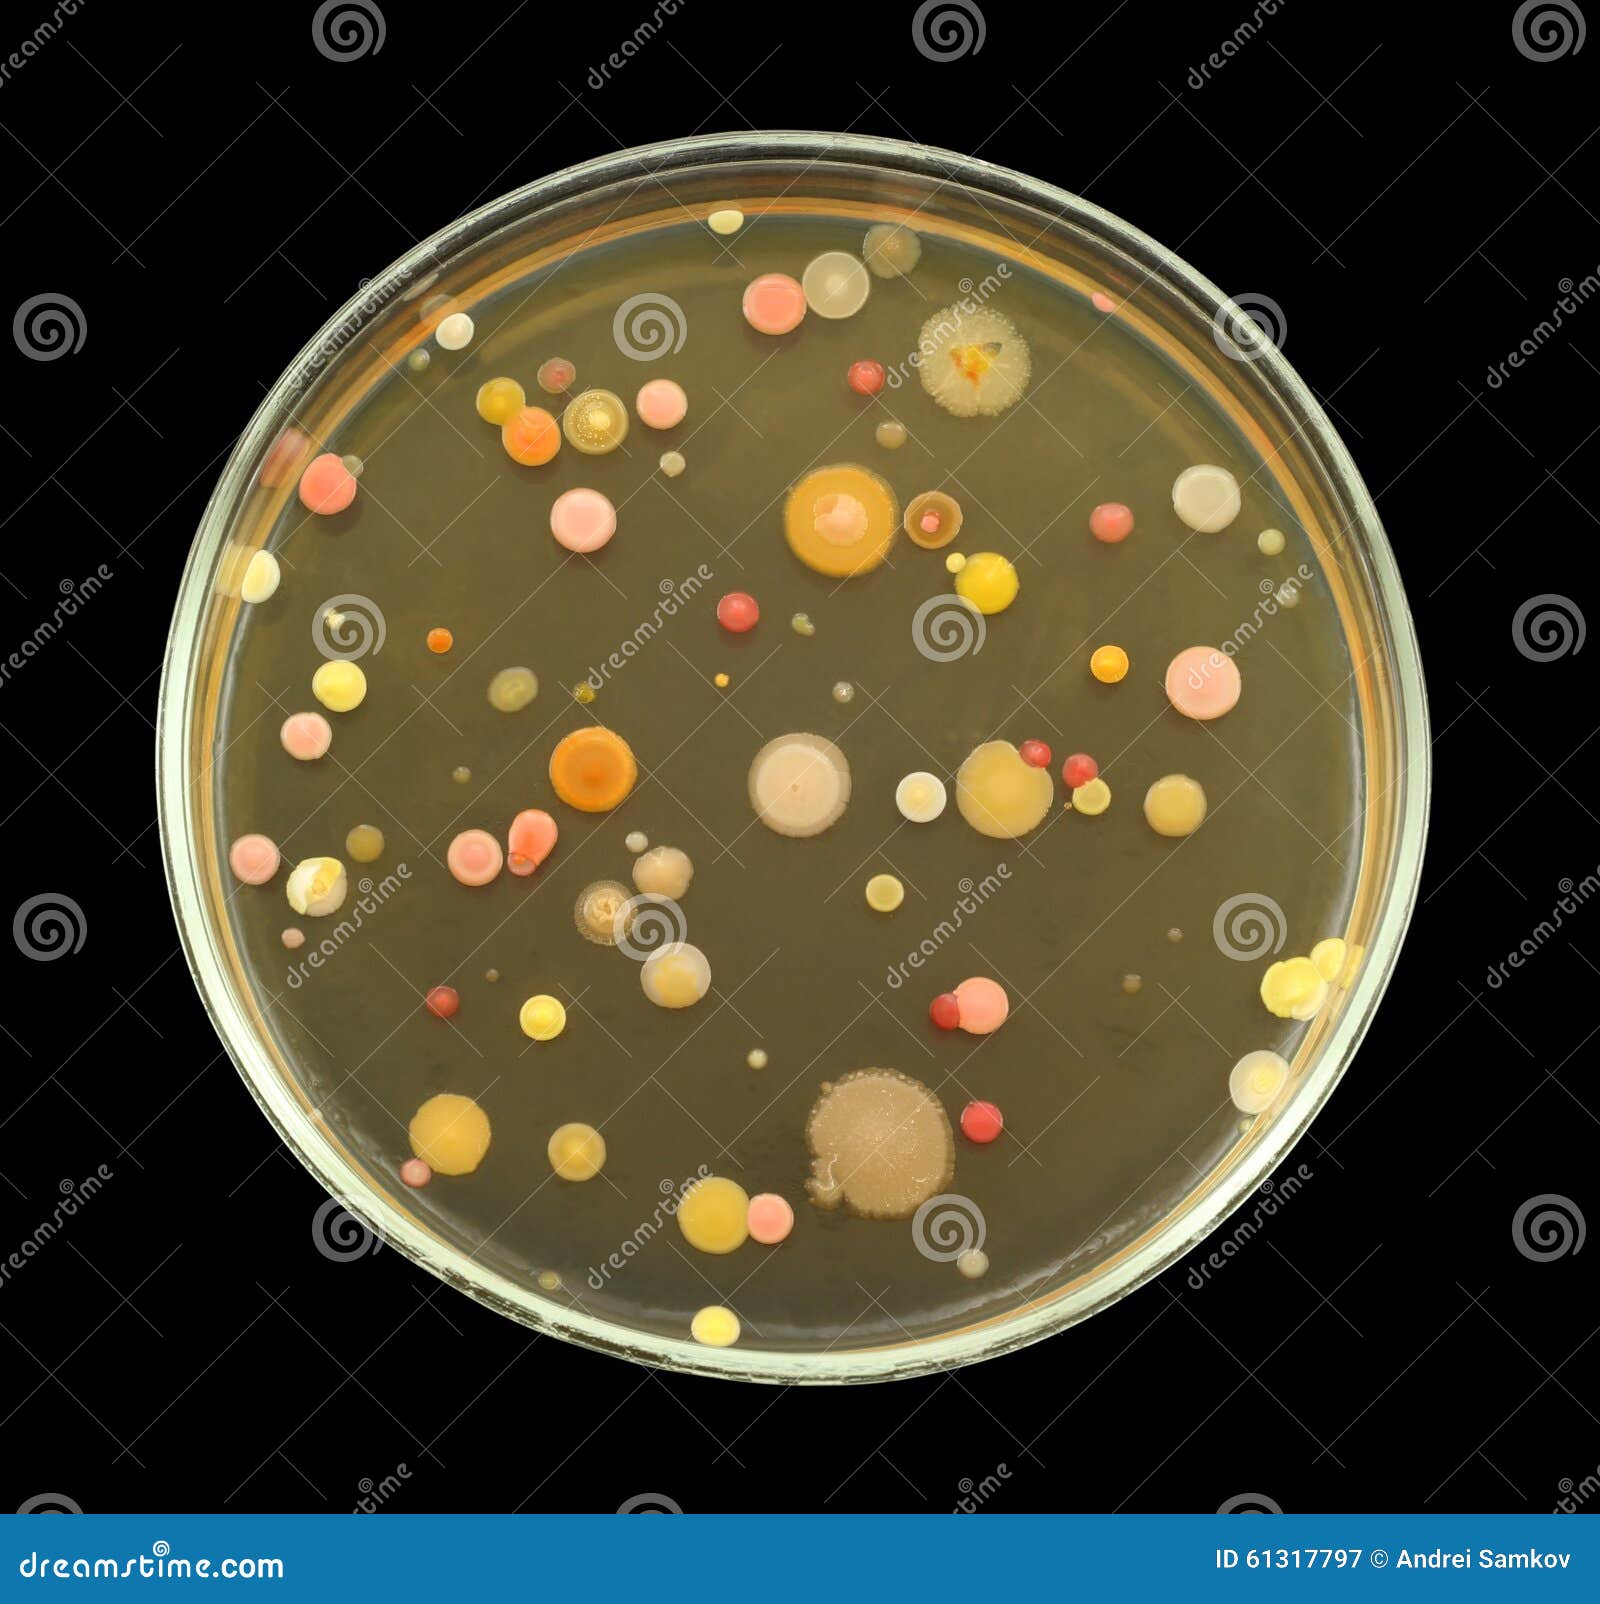

Омч это в микробиологии
Термостат ksd301 nc
География 6 класс учебник стр 168 вопросы
Шпаклевка гипсокартона инструкция
Аудиокниги слушать истинная 3
The north force
Литературное чтение 5 класс поговорки
Микро и макроэволюции в биологии
Читает живые в помощи 40 раз
Половина зимы
L цистеин что это
Какой древний духовой инструмент является самым древним
Ютуб я все сказал
Пайдоиши дини
Омч это в микробиологии 110 фотографий